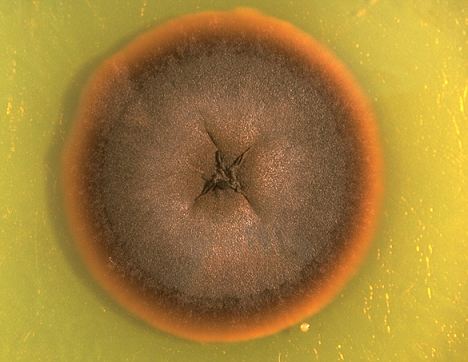
Exophiala

Istraživanje je provedeno u više od stotinu gradova na svijetu, a najviše je uzoraka uzeto iz domaćinstava u Sloveniji. Osim u perilicama suđa, gljivica je pronađena i na mašinama za rublje, ali u znatno manjim postocima.
Istraživanje je provedeno u više od stotinu gradova na svijetu, a najviše je uzoraka uzeto iz domaćinstava u Sloveniji. Osim u perilicama suđa, gljivica je pronađena i na mašinama za rublje, ali u znatno manjim postocima.
Gljivica može preživjeti kemikalije koje se koriste pri pranju suđa, kao i visoke temperature, a ako dođe u doticaj s čovjekom može biti itekako štetna. Prvo napada pluća, a potom izaziva razne infekcije, koje mogu biti smrtonosne.
- To što ih pronalazimo na tako ekstremnim područjima potvrđuje kako su ti organizmi evoulirali. To bi mogao biti velik problem za ljude i njihovo zdravlje - rekao je biolog Polona Zalar iz Ljubljane.
(Jutarnji.hr, DEPO PORTAL/eb)
PODIJELI NA
Depo.ba pratite putem društvenih mreža Twitter i Facebook
